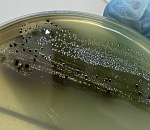
Партию курицы с сальмонеллой выявили эксперты в Астрахани

Новости кратко
11:50
Ночью в пожаре погиб астраханец
04.04
118
11:00
18:25
16:58
16:14
15:30
14:49
Астраханское кладбище утонуло в мусоре
03.04
681
13:59
13:01
12:26
12:01
11:18
10:43
Астраханцы увидят гибель кометы
03.04
416
10:23
Социальные сети


| Пн | Вт | Ср | Чт | Пт | Сб | Вс |